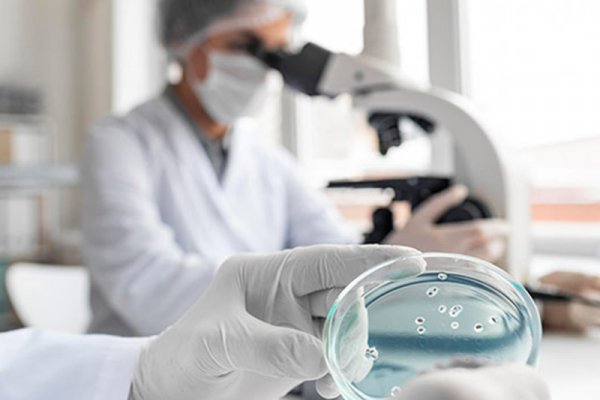

Die Neuerkrankungsrate chronisch entzündlicher Darmerkrankungen im Kindesalter steigt in Deutschland. Sie ist die Folge einer - im Detail unklaren – fehlgeleiteten Immunabwehr des Darmes. Der zum Teil schwere, u.U. lebensbedrohliche Verlauf führt zu erheblich reduzierter Lebensqualität und einer lebenslangen Therapie.
Mit diesem Forschungsprojekt sollen bestimmte Ursachen identifiziert werden, die dazu beitragen, Stoffwechselwege zu blockieren und Entzündungsprozesse auszulösen. Bestätigt sich die vermutete Ursache, könnte eine innovative antientzündliche Therapie entwickelt werden.